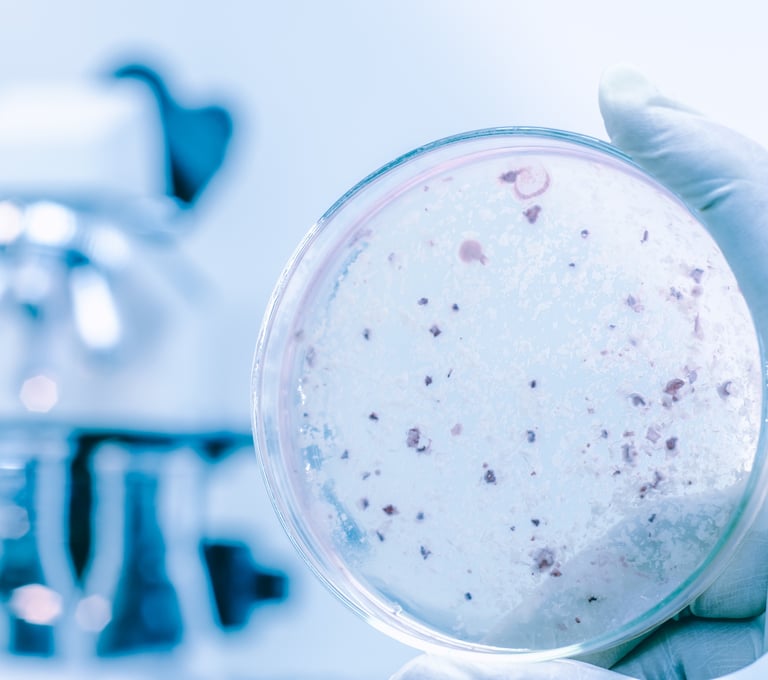
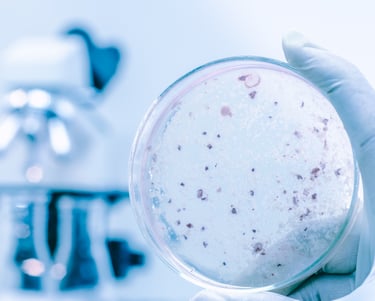

Roedores
We have made quality of our habit. It’s not something that we just strive for – we live by this principle every day.


Rastreros
We have made quality of our habit. It’s not something that we just strive for – we live by this principle every day.


Voladores
We have made quality of our habit. It’s not something that we just strive for – we live by this principle every day.


Xilófagos
We have made quality of our habit. It’s not something that we just strive for – we live by this principle every day.


Legionella
We have made quality of our habit. It’s not something that we just strive for – we live by this principle every day.

Fitosanitarios
We have made quality of our habit. It’s not something that we just strive for – we live by this principle every day.


APPCC
We have made quality of our habit. It’s not something that we just strive for – we live by this principle every day.























